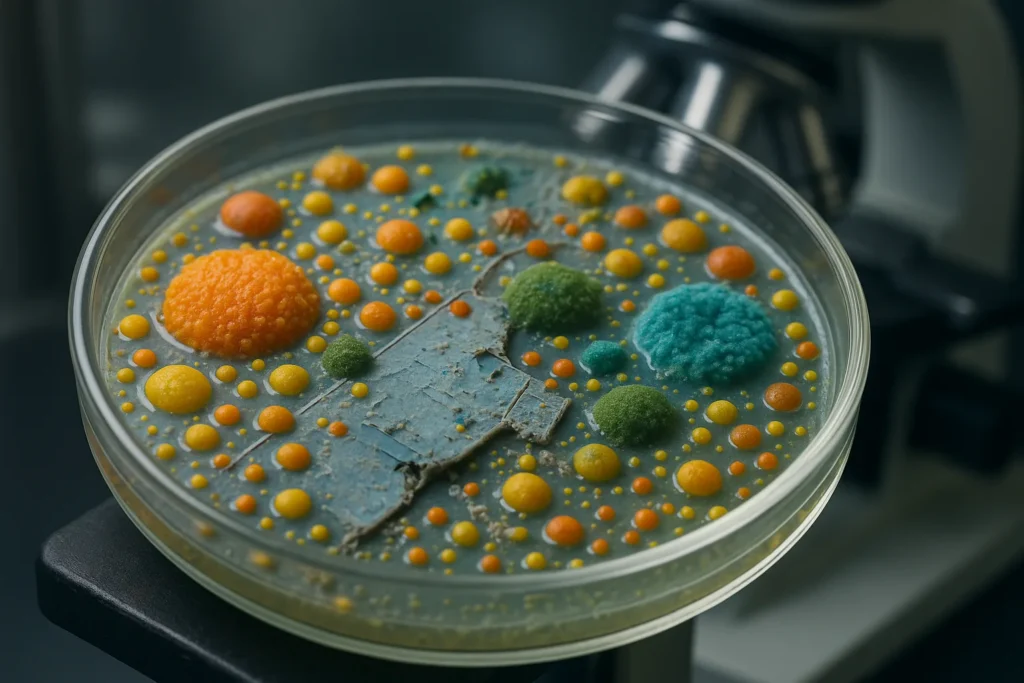
Bacteria biodegrading plastic biofilm

Plastic pollution is everywhere — in oceans, soils, and even the air we breathe. But nature is not entirely defenseless. A comprehensive 2024 review published in FEMS Microbiology Reviews maps out exactly how microorganisms break down plastics at the molecular level, revealing a sophisticated biochemical toolkit that bacteria and fungi have evolved to tackle synthetic polymers. Understanding plastic biodegradation bacteria is key to developing new waste management strategies.
How Do Bacteria Colonize and Break Down Plastic?
The biodegradation process begins when microorganisms attach to a plastic surface and form a biofilm — a structured community often called the “plastisphere.” Once established, these microbial colonies secrete extracellular enzymes that attack the polymer chains. The process follows a general sequence:
- Surface colonization: Bacteria adhere to the plastic and form biofilms.
- Enzymatic depolymerization: Secreted enzymes cleave long polymer chains into shorter oligomers and monomers.
- Uptake and metabolism: The resulting small molecules are transported into cells and fed into central metabolic pathways for energy and growth.
This is not a single mechanism but a diverse collection of biochemical strategies, each tailored to the specific chemistry of different plastic types.
Degradation Pathways for Major Plastics
PET (Polyethylene Terephthalate)
PET degradation is the best-understood pathway, largely thanks to the discovery of Ideonella sakaiensis and its PETase enzyme. This enzyme hydrolyzes PET into mono(2-hydroxyethyl) terephthalic acid (MHET), which is further broken down by MHETase into terephthalic acid and ethylene glycol — both of which bacteria can metabolize.
Polyethylene (PE) and Polystyrene (PS)
These carbon-backbone polymers are far more resistant to biodegradation. The review details how oxidative enzymes such as laccases and alkane hydroxylases initiate attack on PE, while PS degradation involves similar oxidative mechanisms. Both processes are significantly slower than PET hydrolysis and often require prior UV exposure or physical weathering to proceed efficiently.
PLA and PHA (Bioplastics)
Polylactic acid (PLA) and polyhydroxyalkanoates (PHA) are designed to biodegrade, and the enzymatic pathways are correspondingly well-developed. Proteinase K and other serine proteases efficiently break down PLA, while PHA depolymerases target the ester bonds in PHA. These pathways are widespread in soil and compost environments.
Why This Research Matters
Understanding the biochemistry of plastic biodegradation bacteria opens doors to practical applications. Enzyme engineering could enhance natural degradation rates, making biological recycling of plastics feasible at industrial scale. Researchers are already working on improved PETase variants with higher thermal stability and catalytic efficiency.
The review also highlights significant knowledge gaps. For many plastics, the complete metabolic pathways remain unknown, and the environmental conditions that promote or inhibit biodegradation need further study. Additionally, the ecological consequences of microbial plastic degradation — including the fate of intermediate breakdown products — require careful evaluation.
Source: “The biochemical mechanisms of plastic biodegradation.” FEMS Microbiology Reviews, 2024. Read the full review.
FAQ
Can bacteria fully break down plastic?
Some bacteria can fully mineralize certain plastics like PET and PHA into CO₂ and water. However, more resistant plastics like polyethylene and polystyrene are only partially degraded by known microbial processes and require further research.
What is the plastisphere?
The plastisphere is the community of microorganisms — bacteria, fungi, and algae — that colonize the surface of plastic debris in the environment, forming biofilms that can initiate biodegradation.
Which enzyme breaks down PET plastic?
PETase, first identified in the bacterium Ideonella sakaiensis, is the key enzyme that hydrolyzes PET into smaller molecules. It works alongside MHETase to complete the degradation into terephthalic acid and ethylene glycol.
How long does it take bacteria to degrade plastic?
The timeline varies enormously. Engineered PETase enzymes can degrade PET in days to weeks under optimized conditions, while natural biodegradation of polyethylene in the environment can take decades or longer.